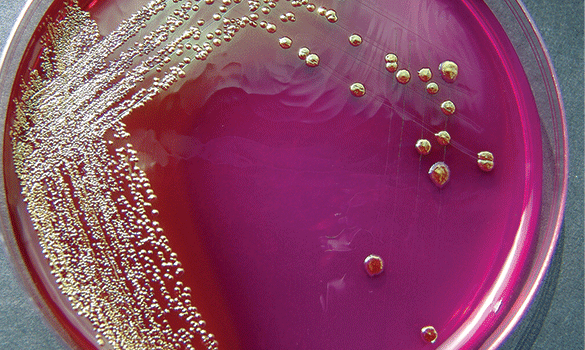

Does your water taste funny? Smell odd? Look, well….not normal? We can help.
Do you notice that your water seems “off”? If your water tastes metallic, smells like rotten eggs, or leaves spots and stains, you may have a water quality problem. Whether you’ve noticed one indication or several, or whether you haven’t noticed a problem but you want to find out for sure, our EcoWater Professionals are qualified to perform an easy and comprehensive in-home water analysis and recommend the right solution – whether it is hard water treatment or a remedy for another water issue.
























(0) Water symptoms selected.

Do you notice spots on dishes, shower doors, or fixtures?
Hard water is water that has a high mineral content. It’s a natural result of minerals like calcium and magnesium accumulating during the water cycle, and it can happen with well water and even city water. The hardness of water is measured in grains per gallon (gpg). One grain is equivalent to 17.1 milligrams of calcium or magnesium dissolved in one liter of water. The more calcium and magnesium dissolved in the water, the harder the water becomes. This is why certain cities and counties within the same state can have varying degrees of water hardness.
The effects of hard water are fairly easy to spot:
Hard water can be tough on your home, your skin and your wallet. A water softener counteracts those effects by creating better quality water that extends the life of your appliances while also helping you and your home look and feel better.
 Chlorine & Chloramines
Chlorine & ChloraminesDoes your water smell or taste like a swimming pool?
Chlorine is commonly known to maintain swimming pools. It is also used in common commercial and household disinfectant products such as bleach. Often, municipalities use chlorine in the disinfection of the public water supply to manage bacteria levels in drinking water and to kill other potentially harmful agents. Chloramines (Chlorine + Ammonia) is an alternative to using chlorine. The typical purpose of chloramines is to provide longer-lasting water treatment as the water moves through pipes to consumers.
Chlorine, even at acceptable household levels, can affect the taste of food and beverages and contribute to dry eyes, skin irritation and can exacerbate conditions such as eczema.
An EcoWater refiner or carbon-based filter can be used to remove both chlorine and chloramines throughout the home or can be accomplished with a “point-of-use” filter for single faucet water treatment. Our water treatment specialists understand how to treat your local water and can provide the best recommendation for your home and family.
 Iron
IronDoes your water taste metallic or do you notice reddish, rust-like stains?
The culprit for these hard to remove stains or that “off” taste could be due to high levels of iron in your water. Iron water is caused by water passing through iron-bearing rocks. Because iron accounts for 5% of the earth’s crust, it can be found in just about all types of water supplies and in different forms.
The type of iron present is important when considering the type of water treatment solution. Water that comes out of the faucet clear, but turns red or brown after standing is ferrous iron, also referred to as ‘clear water iron’. Water which is yellow or reddish immediately from the faucet is ferric iron, also known as ‘red water iron’. Ferric iron has already oxidized and come out of solution into a particle form.
Iron in water can stain sinks and laundry and form scale in pipes and water-using appliances which leads to clogged filters, pipes and showerheads over time. While you may be able to spot treat iron in your water with an acidic cleaner, the most effective way is with a water softener or specialty filter.
 Manganese
ManganeseDoes your water taste metallic, look brackish or do you notice brownish stains?
Similar to iron, manganese is a naturally occurring mineral that is present in soils, rocks, and sediment. While it is an essential mineral, concentrations higher than 0.5 parts per million (ppm) in water are considered unhealthy for human consumption. Well water could have concentrations as high as 2 to 3 parts per million, or six times above the safe threshold.
Levels as low as 0.05 ppm will leave brownish stains in sinks. It can appear as a floating film on the surface of standing water. You may also notice a black discoloration in your dishwasher, because detergents raise the pH of the water high enough (>8) to allow manganese to precipitate out of solution.
Similar to iron, manganese can be completely dissolved in water or is precipitated out of solution and makes water appear black straight from the tap. While a softener is able to remove dissolved manganese from water, many other factors (pH, presence of other minerals, and level of total dissolved solids (TDS)) can reduce the efficacy of this solution. Manganese removal is best removed using a specialty whole home filter. An EcoWater Pro can test your water and determine the best treatment solution for you.
 Hydrogen Sulfide
Hydrogen SulfideDoes your water smell like rotten eggs?
The presence of Hydrogen Sulfide is caused by decaying vegetation and oil deposits beneath the earth’s surface. Sulfur in your water supply is easily recognized by its offensive odor. Hydrogen sulfide gas causes the “rotten-egg” or sulfur water smell. If you notice this odor only when using hot water, the problem may be simply fixed by servicing the water heater. If your cold and hot water, however, is found to have traces of hydrogen sulfide, you may need to invest in a point-of-use drinking water system or point-of-entry filter.
Water containing Hydrogen Sulfide can alter the look and taste of beverages and cooked foods. The water can also corrode plumbing metals, such as iron, steel, copper and brass, as well as exposed metals in washing machines and other water-using appliances. Exposure to water containing Hydrogen Sulfide can darken silverware and discolor copper and brass fixtures.
 Cloudy Water
Cloudy WaterDoes your water look foggy or do you notice sand or dirt in your water?
If you draw your water from a well, lake, stream or pond there is a high possibility that you have experienced cloudiness in your water at one time or another. It is caused by sand, dirt or other inorganic matter getting into wells, or by run-off of matter into the water supply. This cloudiness, or turbidity, is simply dirt or other suspended solids in your water, which gives it a cloudy, milky, foggy appearance.
While many people consider water turbidity a visual or aesthetic concern, if left untreated, it can lead to more troubling plumbing issues down the road. Turbidity can clog pipes and the small water-bearing openings in your faucets – creating wear on valves, seats and washers, which can lead to costly repairs. Turbidity can also cause staining in sinks, fixtures and laundry.
There are several types of systems and filters that can be used for treating sediment and turbidity problems in the home. An EcoWater Pro can evaluate your water supply and identify the best solution for your needs.
 Low pH
Low pHDoes your water have a metallic taste or do you notice bluish-green stains inside your toilet tank or on your fixtures?
If your water has a low pH (less than 7) it is may be considered acidic. Common causes for acidic water are acid rainfall due to atmospheric carbon dioxide and other airborne pollutants, runoff from mining spoils, and decomposition of plant materials.
Acidity in water can have an adverse effect on the taste and quality of your water, as well as household pipes and fixtures. Acidic water can cause fixtures to have blue staining (from copper pipes) or rust staining (from iron pipes). The main problem is the damage it can do to copper or iron plumbing. The water slowly eats away at the plumbing and water heater tank, eventually leaving holes.
If you suspect that you may have a low pH issue, or would like to have your water tested for acidity or contaminants, contact an EcoWater Pro. Our water treatment specialists understand the problem water challenges and commonly occurring contaminants affecting their region.
 Arsenic
ArsenicArsenic in water can be hard to detect, because it is both odorless and tasteless.
Arsenic can be toxic even in small levels and is a known human carcinogen that may cause cancer and can increase the likelihood of developing other health problems. The only way to identify its presence is to have the water tested through a state certified lab.
While it is regulated by the EPA, arsenic can enter drinking water supplies from erosion of natural deposits in the earth or from agricultural and industrial runoff. You may be at higher risk of having arsenic contaminated water if you rely on a private well, if you live in areas known to have higher concentrations of naturally occurring arsenic, or if you live near a large industrial area or farm.
If you have any questions about your water quality, call your utility provider, or schedule a comprehensive water analysis from your local EcoWater Pro.
 Lead
LeadLead differs from other contaminants in that it rarely occurs naturally in the raw water supply. Lead is more likely to become a problem after the water has left the treatment plant. Lead is a toxic metal that is harmful to human health; there is NO safe level for lead exposure.
The primary source for lead in most drinking water supplies is as a result of corrosion in the household plumbing – lead pipes, lead solder, brass faucets. Homes built before the 1930’s utilized lead pipes. Older homes may also have lead service lines connecting the home’s plumbing to the public water distribution system. Even if your home was built after the 1930’s and has copper pipes, the solder may contain elevated levels of lead. While replacing lead service lines and old fixtures may be desirable, it may not always be feasible.
Some simple methods, such as flushing the faucets before using the water and never using water from the hot-water tap for drinking or cooking, can significantly reduce exposure to lead. If high lead levels still exist, however, a water treatment system may be needed. Potential options include specialty filters, reverse osmosis systems and distillers. Contact your local EcoWater Pro to address your concerns.
 Nitrates
NitratesNitrate is a naturally occurring form of nitrogen, essential for plant growth and often added to soil (fertilizer) to improve productivity. Like some contaminants, it is both tasteless and odorless. When nitrates are not completely absorbed by the soil or the crops, excess can often find itself in groundwater and surface water supplies, which are in turn used in residential drinking water systems.
For homeowners in rural communities or using wells or springs, water should be tested for nitrates by a water treatment professional, as it is harmful to human and animal health. Your local EcoWater Pro can recommend a POU or POE filtration solution to reduce water pollutants, like nitrates, up to 99%.
Microbiologicals
MicrobiologicalsDoes your water smell musty or woody?
Different types of organic matter (algae, mold, and bacteria) can make your water taste earthy or fishy. The micro-organisms which find their way into a water supply can come from a variety of sources including sewage, animal wastes, or dead and decaying animals. Public water systems are required by state and federal governments to provide biologically safe water, however private wells are not regulated. Additionally, even though bacteria is treated and removed from municipal water supplies, the moldy taste the algae imparts to the water may be detected at extremely microscopic levels by some people.
Bacteria in water cannot be seen, tasted, or smelled and many health-related symptoms are not immediate. Therefore, the only way to reliably determine if water is contaminated is by a laboratory test. An EcoWater Pro can assist with both businesses and homeowners if this is of concern.
 Pharmaceuticals
PharmaceuticalsIn total, the U.S. EPA requires drinking water treatment plants to test for almost 90 different contaminants, however pharmaceuticals and any type of drug are currently absent from this list. The impact of most of these “chemicals of emerging concern” on the health of people remains unclear.
Even though trace pharmaceutical compounds have been found in drinking supplies across North America and there is no evidence that they pose a health risk, more and more consumers want to protect their drinking water from any threats, potential or genuine, that compromise drinking water quality.
While currently no removal standards exist and no water treatment system can claim to remove 100% of pharmaceutical traces from your water, EcoWater’s point-of-use drinking water systems have been proven to remove molecular compounds. Contact your local EcoWater Pro today.
Please enter the following information to learn more about how EcoWater can improve the water in your home.
Veuillez entrer les informations suivantes pour découvrir comment EcoWater peut améliorer l’eau de votre domicile.
Although an EcoWater dealer does not support your area currently, we are happy to assist you with an alternative solution. You can order, with free shipping, a top name-brand filtration or softener system by shopping at EcoPureHome.com. Any installation services below can then assist with installation, or you can simply install the system yourself.
Bien qu'il n'y ait pas actuellement un revendeur EcoWater dans votre région, nous sommes heureux de vous proposer une solution alternative. Vous pouvez commander, avec de l'expédition gratuite, un système de filtration ou d’adoucisseur d'eau d'une marque réputée en faisant vos achats auprès de EcoPureHome.com. L’un des services d’installation ci-dessous peut vous aider à compléter l’installation ou vous pouvez simplement installer le système vous-même.
©2026 EcoWater Systems LLC. All rights reserved...